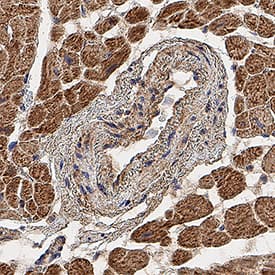

Human IL-13 R alpha1 Antibody
R&D Systems, part of Bio-Techne | Catalog # AF152


Key Product Details
Species Reactivity
Validated:
Cited:
Applications
Validated:
Cited:
Label
Antibody Source
Product Specifications
Immunogen
Ala27-Thr343 (Thr130Ile)
Accession # Q5JSL4
Specificity
Clonality
Host
Isotype
Endotoxin Level
Scientific Data Images for Human IL-13 R alpha1 Antibody
Cell Proliferation Induced by IL‑13 and Neutralization by Human IL‑13 R alpha1 Antibody.
Recombinant Human IL-13 (213-ILB) stimulates prolif-eration in the TF-1 human erythroleukemic cell line in a dose-dependent manner (orange line). Proliferation elicited by Recombinant Human IL-13 (10 ng/mL) is neutralized (green line) by increasing concentrations of Goat Anti-Human IL-13 Ra1 Antigen Affinity-purified Polyclonal Antibody (Catalog # AF152). The ND50 is typically 1.00-12.0 µg/mL.Detection of IL-13 R alpha1 in Human Granulocytes by Flow Cytometry.
Human whole blood granulocytes were stained with Goat Anti-Human IL-13 Ra1 Antigen Affinity-purified Polyclonal Antibody (Catalog # AF152, filled histogram) or control antibody (AB-108-C, open histogram), followed by Phycoerythrin-conjugated Anti-Goat IgG Secondary Antibody (F0107).IL‑13 R alpha1 in Human Skin.
IL-13 Ra1 was detected in immersion fixed paraffin-embedded sections of human skin using Goat Anti-Human IL-13 Ra1 Antigen Affinity-purified Polyclonal Antibody (Catalog # AF152) at 15 µg/mL overnight at 4 °C. Tissue was stained using the Anti-Goat HRP-DAB Cell & Tissue Staining Kit (brown; CTS008) and counterstained with hematoxylin (blue). View our protocol for Chromogenic IHC Staining of Paraffin-embedded Tissue Sections.Applications for Human IL-13 R alpha1 Antibody
CyTOF-ready
Flow Cytometry
Sample: Human whole blood granulocytes
Immunohistochemistry
Sample: Immersion fixed paraffin-embedded sections of human skin and human heart.
Western Blot
Sample: Recombinant Human IL-13 R alpha1 Fc Chimera (Catalog # 146-IR)
Neutralization
Reviewed Applications
Read 2 reviews rated 3 using AF152 in the following applications:
Formulation, Preparation, and Storage
Purification
Reconstitution
Formulation
*Small pack size (-SP) is supplied either lyophilized or as a 0.2 µm filtered solution in PBS.
Shipping
Stability & Storage
- 12 months from date of receipt, -20 to -70 °C as supplied.
- 1 month, 2 to 8 °C under sterile conditions after reconstitution.
- 6 months, -20 to -70 °C under sterile conditions after reconstitution.
Background: IL-13 R alpha 1
Two type 1 membrane proteins belonging to the hemopoietin receptor family have been cloned and shown to bind IL-13 with differing affinities. The lower affinity IL-13 binding protein, previously designated IL-13 R alpha, IL-13 R alpha' or NR4, is now referred to as IL-13 R alpha1. The high-affinity IL-13 binding protein, previously also designated IL-13 R or IL-13 R alpha', is now referred to as IL-13 R alpha2. The human IL-13 R alpha1 was originally cloned based on sequence homology to the mouse IL-13 R alpha1. The IL‑13 R alpha1 cDNA encodes a 427 amino acid (aa) residue precursor protein with a putative 21 aa residue signal peptide, a 324 aa residue extracellular domain, a 23 aa residue transmembrane region and a 59 aa residue cytoplasmic tail. Human and mouse IL-13 R alpha1 share 76% aa sequence identity. The extracellular domain of IL‑13 R alpha1 is also closely related to that of IL-13 R alpha2. IL-13 R alpha1 has been shown to combine with the IL-4 R alpha to form a high-affinity receptor complex capable of transducing an IL-13-dependent proliferative signal. The role of IL-13 R alpha2 in IL-13 signaling remains to be elucidated.
References
- Caput, D. et al. (1996) J. Biol. Chem. 271:16921.
- Donaldson, D.D. et al. (1998) J. Immunol. 161:2317.
- Aman, M.J. et al. (1996) J. Biol. Chem. 271:29265.
- Hilton, D.J. et al. (1996) Proc. Natl. Acad. Sci. USA 93:497.
- Zhang, J.G. et al. (1997) J. Biol. Chem. 272:9474.
Long Name
Alternate Names
Gene Symbol
UniProt
Additional IL-13 R alpha 1 Products
Product Documents for Human IL-13 R alpha1 Antibody
Product Specific Notices for Human IL-13 R alpha1 Antibody
For research use only